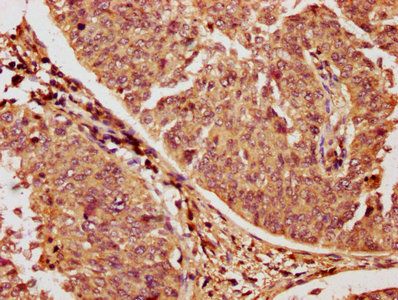
RAC1 Antibody

You have no items in your shopping cart.
Recombinant p21 Antibody
Description
Research Area
Images & Validation
−| Tested Applications | IHC-P, WB |
|---|---|
| Dilution Range | Immunohistochemistry (FFPE): 1-2ug/ml for 30 min at RT,Western blot: 2-4ug/ml |
| Reactivity | Human |
| Application Notes |
Key Properties
−| Antibody Type | Primary Antibody |
|---|---|
| Host | Rabbit |
| Clonality | Recombinant |
| Isotype | Rabbit IgG |
| Clone No. | CIP1/4377R |
| Immunogen | A portion of amino acids 1-100 from the human protein was used as the immunogen for the recombinant p21 antibody. |
| Purification | Protein A affinity chromatography |
| Conjugation | Unconjugated |
Storage & Handling
−| Storage | Maintain refrigerated at 2-8°C for up to 2 weeks. For long term storage store at -20°C in small aliquots to prevent freeze-thaw cycles. |
|---|---|
| Buffer/Preservatives | 0.2 mg/ml in 1X PBS with 0.1 mg/ml rAlbumin and 0.05% sodium azide |
| Expiration Date | 12 months from date of receipt. |
| Disclaimer | For research use only |
Similar Products
−P21 Recombinant Rabbit Monoclonal Antibody [orb1499284]
FC, ICC, IF, IHC-Fr, IHC-P, WB
Human
Rabbit
Recombinant
Unconjugated
25 μl, 50 μl, 100 μl

Quality Guarantee
Explore bioreagents carefree to elevate your research. All our products are rigorously tested for performance. If a product does not perform as described on its datasheet, our scientific support team will provide expert troubleshooting, a prompt replacement, or a refund. For full details, please see our Terms & Conditions and Buying Guide. Contact us at support@biorbyt.com.

Analysis of HuProt (TM) microarray containing more than 19000 full-length human proteins using p21 antibody. These results demonstrate the foremost specificity of the CIP1/4377R mAb. Z- and S- score: The Z-score represents the strength of a signal that an antibody (in combination with a fluorescently-tagged anti-IgG secondary Ab) produces when binding to a particular protein on the HuProt (TM) array. Z-scores are described in units of standard deviations (SD's) above the mean value of all signals generated on that array. If the targets on the HuProt (TM) are arranged in descending order of the Z-score, the S-score is the difference (also in units of SD's) between the Z-scores. The S-score therefore represents the relative target specificity of an Ab to its intended target.

IHC staining of FFPE human lung carcinoma with recombinant p21 antibody (clone CIP1/4377R). HIER: boil tissue sections in pH9 10mM Tris with 1mM EDTA for 20 min and allow to cool before testing.

IHC staining of FFPE human colon carcinoma with recombinant p21 antibody (clone CIP1/4377R). HIER: boil tissue sections in pH9 10mM Tris with 1mM EDTA for 20 min and allow to cool before testing.
Quick Database Links
UniProt Details
−Documents Download
Request a Document
Protocol Information
Recombinant p21 Antibody (orb699682)
Participating in our Biorbyt product reviews program enables you to support fellow scientists by sharing your firsthand experience with our products.
Login to Submit a Review